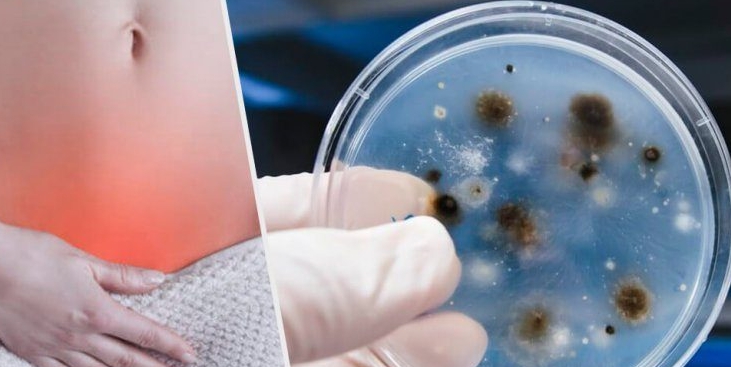

본 블로그의 글에 제휴마케팅이 포함되어 일정 수수료를 제공받을 수 있습니다
질염은 여성의 질에 발생하는 염증으로, 다양한 원인에 의해 발생할 수 있습니다. 질염의 증상으로는 질 분비물의 색상, 냄새, 양의 변화, 질 가려움증 또는 자극, 성교 시 통증, 배뇨 시 통증 등이 있습니다. 아래에서는 질염의 주요 종류와 그 원인에 대해 자세히 알아보겠습니다.

질염의 주요 종류
1. 세균성 질염 (Bacterial Vaginosis)
세균성 질염은 질 내 박테리아 균형이 깨질 때 발생합니다. 정상적으로 질 내에 존재하는 유익한 박테리아가 줄어들고, 유해한 박테리아가 증가하면서 발생합니다. 주로 성교와 관련이 있지만, 성생활이 없는 여성에게도 발생할 수 있습니다. 증상으로는 회색 또는 흰색의 악취 나는 분비물이 있습니다.



2. 칸디다 질염 (Yeast Infection)
칸디다 질염은 칸디다 알비칸스(Candida albicans)라는 곰팡이에 의해 발생합니다. 이 곰팡이는 정상적으로 질 내에 존재하지만, 특정 조건에서 과도하게 증식하여 감염을 일으킵니다. 주로 항생제 사용, 면역력 저하, 고당분 식단 등이 원인이 될 수 있습니다. 증상으로는 가려움, 두꺼운 흰색 분비물 등이 있습니다.
3. 트리코모나스 질염 (Trichomoniasis)
트리코모나스 질염은 트리코모나스 바지날리스(Trichomonas vaginalis)라는 기생충에 의해 발생하는 성병입니다. 주로 성접촉을 통해 전파되며, 남성에게는 증상이 없지만 여성에게는 악취 나는 황록색 분비물, 가려움, 통증 등을 유발할 수 있습니다.
4. 비감염성 질염 (Non-infectious Vaginitis)
비감염성 질염은 알레르기 반응이나 자극에 의해 발생합니다. 예를 들어, 질 세척제, 향이 있는 비누, 스프레이, 피임약 등이 원인이 될 수 있습니다. 또한, 폐경 후 에스트로겐 감소로 인한 질 건조증(위축성 질염)도 비감염성 질염의 한 형태입니다.



질염의 원인
호르몬 변화
임신, 출산, 폐경 등으로 인한 호르몬 변화는 질염의 주요 원인이 될 수 있습니다. 특히 폐경 후 에스트로겐 감소는 질 내 벽을 얇게 하고 건조하게 만들어 질염을 유발할 수 있습니다.
성병
일부 성병은 질염을 유발할 수 있습니다. 트리코모나스, 임질, 클라미디아 등이 그 예입니다. 성병에 의한 질염은 주로 성접촉을 통해 전파됩니다.



항생제 사용
항생제는 몸 안의 유익한 박테리아까지 죽일 수 있어, 질 내 균형을 깨뜨려 칸디다 질염을 유발할 수 있습니다.
개인 위생 제품
향이 있는 비누, 질 세척제, 스프레이 등 개인 위생 제품은 질 내 환경을 자극하여 질염을 유발할 수 있습니다. 이러한 제품의 사용을 피하는 것이 좋습니다.



질염약
질염 치료에는 질염의 원인에 따라 다양한 약물이 사용됩니다. 칸디다 질염, 세균성 질염, 트리코모나스 질염 등 각 유형별로 다른 치료 약물이 필요합니다.
아래 글에 질염약에 대한 설명이 잘 정리되어 있어 한 번 확인해보시기 바랍니다.



예방 및 관리 방법
- 올바른 위생 관리: 질 내 세균 균형을 유지하기 위해 향이 없는 비누를 사용하고, 성교 후에는 반드시 청결을 유지합니다.
- 적절한 의복 착용: 통기성이 좋은 속옷을 착용하고, 너무 꽉 끼는 옷은 피합니다.
- 항생제 남용 자제: 항생제는 꼭 필요한 경우에만 사용하고, 사용 후에는 프로바이오틱스를 섭취하여 유익한 박테리아를 회복합니다.
- 규칙적인 검진: 정기적으로 산부인과 검진을 받아 질염을 조기에 발견하고 치료합니다.
질염은 다양한 원인에 의해 발생할 수 있으므로, 증상이 나타날 경우 전문가의 상담을 받아 적절한 치료를 받는 것이 중요합니다.


